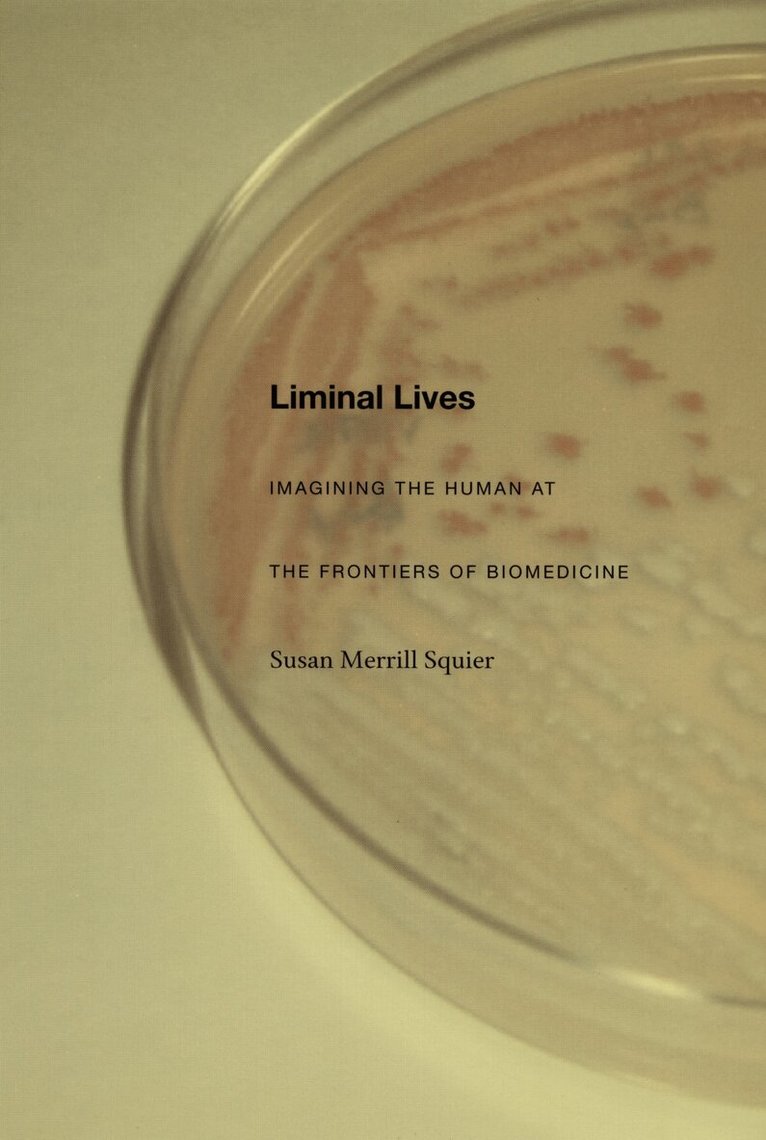

Susan Merrill Squier – författare
Visar alla böcker från författaren Susan Merrill Squier. Handla med fri frakt och snabb leverans.
10 produkter
10 produkter
Del 1 - Graphic Medicine
Graphic Medicine Manifesto
Häftad, Engelska, 2015
417 kr
Skickas
This inaugural volume in the Graphic Medicine series establishes the principles of graphic medicine and begins to map the field. The volume combines scholarly essays by members of the editorial team with previously unpublished visual narratives by Ian Williams and MK Czerwiec, and it includes arresting visual work from a wide range of graphic medicine practitioners. The book’s first section, featuring essays by Scott Smith and Susan Squier, argues that as a new area of scholarship, research on graphic medicine has the potential to challenge the conventional boundaries of academic disciplines, raise questions about their foundations, and reinvigorate literary scholarship—and the notion of the literary text—for a broader audience. The second section, incorporating essays by Michael Green and Kimberly Myers, demonstrates that graphic medicine narratives can engage members of the health professions with literary and visual representations and symbolic practices that offer patients, family members, physicians, and other caregivers new ways to experience and work with the complex challenges of the medical experience. The final section, by Ian Williams and MK Czerwiec, focuses on the practice of creating graphic narratives, iconography, drawing as a social practice, and the nature of comics as visual rhetoric. A conclusion (in comics form) testifies to the diverse and growing graphic medicine community. Two valuable bibliographies guide readers to comics and scholarly works relevant to the field.
Del 20 - Graphic Medicine
PathoGraphics
Narrative, Aesthetics, Contention, Community
Inbunden, Engelska, 2020
1 431 kr
Skickas inom 5-8 vardagar
Culturally powerful ideas of normalcy and deviation, individual responsibility, and what is medically feasible shape the ways in which we live with illness and disability. The essays in this volume show how illness narratives expressed in a variety of forms—biographical essays, fictional texts, cartoons, graphic novels, and comics—reflect on and grapple with the fact that these human experiences are socially embedded and culturally shaped. Works of fiction addressing the impact of an illness or disability; autobiographies and memoirs exploring an experience of medical treatment; and comics that portray illness or disability from the perspective of patient, family member, or caregiver: all of these narratives forge a specific aesthetic in order to communicate their understanding of the human condition. This collection demonstrates what can emerge when scholars and artists interested in fiction, life-writing, and comics collaborate to explore how various media portray illness, medical treatment, and disability. Rather than stopping at the limits of genre or medium, the essays talk across fields, exploring together how works in these different forms craft narratives and aesthetics to negotiate contention and build community around those experiences and to discover how the knowledge and experiences of illness and disability circulate within the realms of medicine, art, the personal, and the cultural. Ultimately, they demonstrate a common purpose: to examine the ways comics and literary texts build an audience and galvanize not just empathy but also action.In addition to the editors, the contributors to this volume include Einat Avrahami, Maureen Burdock, Elizabeth J. Donaldson, Ariela Freedman, Rieke Jordan, stef lenk, Leah Misemer, Tahneer Oksman, Nina Schmidt, and Helen Spandler.Chapter 7, “Crafting Psychiatric Contention Through Single-Panel Cartoons,” by Helen Spandler, is available as Open Access courtesy of a grant from the Wellcome Trust. A link to the OA version of this chapter is forthcoming.
Del 20 - Graphic Medicine
PathoGraphics
Narrative, Aesthetics, Contention, Community
Häftad, Engelska, 2020
388 kr
Skickas inom 11-20 vardagar
Culturally powerful ideas of normalcy and deviation, individual responsibility, and what is medically feasible shape the ways in which we live with illness and disability. The essays in this volume show how illness narratives expressed in a variety of forms—biographical essays, fictional texts, cartoons, graphic novels, and comics—reflect on and grapple with the fact that these human experiences are socially embedded and culturally shaped. Works of fiction addressing the impact of an illness or disability; autobiographies and memoirs exploring an experience of medical treatment; and comics that portray illness or disability from the perspective of patient, family member, or caregiver: all of these narratives forge a specific aesthetic in order to communicate their understanding of the human condition. This collection demonstrates what can emerge when scholars and artists interested in fiction, life-writing, and comics collaborate to explore how various media portray illness, medical treatment, and disability. Rather than stopping at the limits of genre or medium, the essays talk across fields, exploring together how works in these different forms craft narratives and aesthetics to negotiate contention and build community around those experiences and to discover how the knowledge and experiences of illness and disability circulate within the realms of medicine, art, the personal, and the cultural. Ultimately, they demonstrate a common purpose: to examine the ways comics and literary texts build an audience and galvanize not just empathy but also action.In addition to the editors, the contributors to this volume include Einat Avrahami, Maureen Burdock, Elizabeth J. Donaldson, Ariela Freedman, Rieke Jordan, stef lenk, Leah Misemer, Tahneer Oksman, Nina Schmidt, and Helen Spandler.Chapter 7, “Crafting Psychiatric Contention Through Single-Panel Cartoons,” by Helen Spandler, is available as Open Access courtesy of a grant from the Wellcome Trust. A link to the OA version of this chapter is forthcoming.
Del 28 - Graphic Medicine
Graphic Medicine Manifesto
Tenth-Anniversary Edition
Häftad, Engelska, 2025
359 kr
Skickas
A decade ago, Graphic Medicine Manifesto established a bold new framework for understanding the intersection of comics and healthcare. It was a call to action—an invitation to rethink the ways we engage with medicine, illness, disability, and caregiving through the power of visual storytelling. Now, ten years later, this landmark volume returns in a special anniversary edition that expands and reimagines its mission for a new era. With a new critical preface, this tenth-anniversary edition reflects on Graphic Medicine Manifesto’s legacy and its impact on healthcare, scholarship, and comics. It reaffirms the power of comics to challenge disciplines, amplify marginalized voices, and transform teaching in a range of health fields. Organized into six sections, the introduction explores the manifesto’s origins and ongoing relevance, its role as a radical tool in comics, the power of storytelling in health education, the expanding influence of graphic medicine on disability studies and the humanities, the importance of community and collaboration in breaking disciplinary silos, and the future of the field. Featuring these newly contextualized insights alongside the original essays and visual narratives by Ian Williams, MK Czerwiec, and other leading practitioners, this new edition reaffirms Graphic Medicine Manifesto as an essential text for scholars, healthcare professionals, creators, and anyone engaging with medicine, illness, and caregiving through the power of comics.
Häftad, Engelska, 1989
665 kr
Skickas inom 10-15 vardagar
Although the themes of women's complicity in and resistance to war have been part of literature from early times, they have not been fully integrated into conventional conceptions of the war narrative. Combining feminist literary criticism with the emerging field of feminist war theory, this collection explores the role of gender as an organizing principle in the war system and reveals how literature perpetuates the ancient myth of ""arms and the man."" The volume shows how the gendered conception of war has both shaped literary texts and formed the literary canon. It identifies and interrogates the conventional war text, with its culturally determined split between warlike men and peaceful women, and it confirms that women's role in relation to war is much more complex and complicitous than such essentializing suggests. The contributors examine a wide range of familiar texts from fresh perspectives and bring new texts to light. Collectively, these essays range in time from the Trojan War to the nuclear age. The contributors are June Jordan, Lorraine Helms, Patricia Francis Cholakian, Jane E. Schultz, Margaret R. Higonnet, James Longenbach, Laura Stempel Mumford, Sharon O'Brien, Jane Marcus, Sara Friedrichsmeyer, Susan Schweik, Carol J. Adams, Esther Fuchs, Barbara Freeman, Gillian Brown, Helen M. Cooper, Adrienne Auslander Munich, and Susan Merrill Squier.
Häftad, Engelska, 2011
603 kr
Skickas inom 10-15 vardagar
To Virginia Woolf, London was a source of creative inspiration, a setting for many of her works, and a symbol of the culture in which she lived and wrote. In a 1928 diary entry, she observed, ""London itself perpetually attracts, stimulates, gives me a play & a story & a poem, without any trouble, save that of moving my legs through the streets."" The city fascinated Woolf, yet her relationship with it was problematic. In her attempts to resolve her developmental struggles as a woman write in a patriarchal society, Woolf shaped and reshaped the image and meaning of London.Using psychoanalytic, feminist, and social theories, Susan Squier explores the transformed meaning of the city in Woolf's essays, memoirs, and novels as it functions in the creation of a mature feminist vision. Squier shows that Woolf's earlier works depict London as a competitive patriarchal environment that excluded her, but her mature works portray the city as beginning to accept the force of female energy. Squier argues that this transformation was made possible by Woolf's creative ability to appropriate and revise the masculine literary and cultural forms of her society. The act of writing, or ""scene making,"" allowed Woolf to break from her familial and cultural heritage and recreate London in her own literary voice and vision.Virginia Woolf and London is based on analyses of Woolf's memoirs, her little-known early and mature London essays, Night and Day, Mrs. Dalloway, Flush, and The Years. By focusing on Woolf's changing attitudes about the city, Squier is able to define Woolf's evolving belief that women could ""reframe"" the city-scape and use it to imagine and create a more egalitarian world. Squier's study offers significant new insights into the interplay between self and society as it shapes the work of a woman writer.A UNC Press Enduring Edition -- UNC Press Enduring Editions use the latest in digital technology to make available again books from our distinguished backlist that were previously out of print. These editions are published unaltered from the original, and are presented in affordable paperback formats, bringing readers both historical and cultural value.
Häftad, Engelska, 2003
369 kr
Skickas inom 5-8 vardagar
A pioneering analysis of radio as both a cultural and material production, Communities of the Air explores radio’s powerful role in shaping Anglo-American culture and society since the early twentieth century. Scholars and radio writers, producers, and critics look at the many ways radio generates multiple communities over the air-from elite to popular, dominant to resistant, canonical to transgressive. The contributors approach radio not only in its own right, but also as a set of practices-both technological and social-illuminating broader issues such as race relations, gender politics, and the construction of regional and national identities. Drawing on the perspectives of literary and cultural studies, science studies and feminist theory, radio history, and the new field of radio studies, these essays consider the development of radio as technology: how it was modeled on the telephone, early conflicts between for-profit and public uses of radio, and amateur radio (HAMS), local programming, and low-power radio. Some pieces discuss how radio gives voice to different cultural groups, focusing on the BBC and poetry programming in the West Indies, black radio, the history of alternative radio since the 1970s, and science and contemporary arts programming. Others look at radio’s influence on gender (and gender’s influence on radio) through examinations of Queen Elizabeth’s broadcasts, Gracie Allen’s comedy, and programming geared toward women. Together the contributors demonstrate how attention to the variety of ways radio is used and understood reveals the dynamic emergence and transformation of communities within the larger society.Contributors. Laurence A. Breiner, Bruce B. Campbell, Mary Desjardins, Lauren M. E. Goodlad, Nina Hunteman, Leah Lowe, Adrienne Munich, Kathleen Newman, Martin Spinelli, Susan Merrill Squier, Donald Ulin, Mark Williams, Steve Wurzler
Häftad, Engelska, 2004
436 kr
Skickas inom 5-8 vardagar
Embryo adoptions, stem cells capable of transforming into any cell in the human body, intra- and inter-species organ transplantation-these and other biomedical advances have unsettled ideas of what it means to be human, of when life begins and ends. In the first study to consider the cultural impact of the medical transformation of the entire human life span, Susan Merrill Squier argues that fiction-particularly science fiction-serves as a space where worries about ethically and socially charged scientific procedures are worked through. Indeed, she demonstrates that in many instances fiction has anticipated and paved the way for far-reaching biomedical changes. Squier uses the anthropological concept of liminality-the state of being on the threshold of change, no longer one thing yet not quite another-to explore how, from the early twentieth century forward, fiction and science together have altered not only the concept of the human being but the contours of human life.Drawing on archival materials of twentieth-century biology; little-known works of fiction and science fiction; and twentieth- and twenty-first century U.S. and U.K. government reports by the National Institutes of Health, the Parliamentary Advisory Group on the Ethics of Xenotransplantation, and the President’s Council on Bioethics, she examines a number of biomedical changes as each was portrayed by scientists, social scientists, and authors of fiction and poetry. Among the scientific developments she considers are the cultured cell, the hybrid embryo, the engineered intrauterine fetus, the child treated with human growth hormone, the process of organ transplantation, and the elderly person rejuvenated by hormone replacement therapy or other artificial means. Squier shows that in the midst of new phenomena such as these, literature helps us imagine new ways of living. It allows us to reflect on the possibilities and perils of our liminal lives.
Inbunden, Engelska, 2017
1 510 kr
Skickas inom 5-8 vardagar
Devised in the 1940s by the biologist C. H. Waddington, the epigenetic landscape is a metaphor for how gene regulation modulates cellular development. As a scientific model, it fell out of use in the late 1960s but returned at the beginning of the twenty-first century with the advent of big-data genomic research because of its utility among scientists across the life sciences to think more creatively about and to discuss genetics. In Epigenetic Landscapes Susan Merrill Squier follows the model’s cultural trail, from its first visualization by the artist John Piper to its use beyond science. Squier examines three cases in which the metaphor has been imaginatively deployed to illustrate complex systems that link scientific and cultural practices: graphic medicine, landscape architecture, and bioArt. Challenging reductive understandings of epigenetics, Squier boldly reclaims the broader significance of the epigenetic landscape as a figure at the nexus of art, design, and science.
Häftad, Engelska, 2017
369 kr
Skickas inom 5-8 vardagar
Devised in the 1940s by the biologist C. H. Waddington, the epigenetic landscape is a metaphor for how gene regulation modulates cellular development. As a scientific model, it fell out of use in the late 1960s but returned at the beginning of the twenty-first century with the advent of big-data genomic research because of its utility among scientists across the life sciences to think more creatively about and to discuss genetics. In Epigenetic Landscapes Susan Merrill Squier follows the model’s cultural trail, from its first visualization by the artist John Piper to its use beyond science. Squier examines three cases in which the metaphor has been imaginatively deployed to illustrate complex systems that link scientific and cultural practices: graphic medicine, landscape architecture, and bioArt. Challenging reductive understandings of epigenetics, Squier boldly reclaims the broader significance of the epigenetic landscape as a figure at the nexus of art, design, and science.